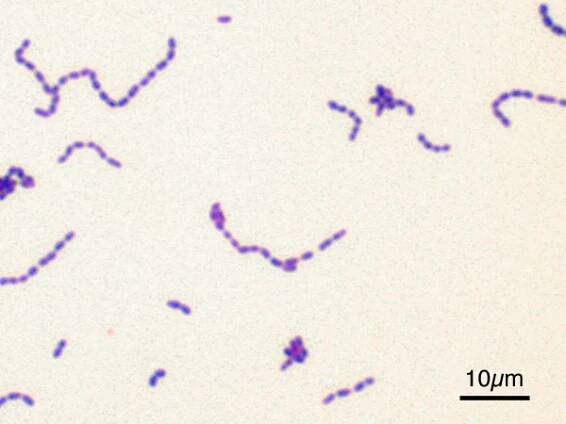
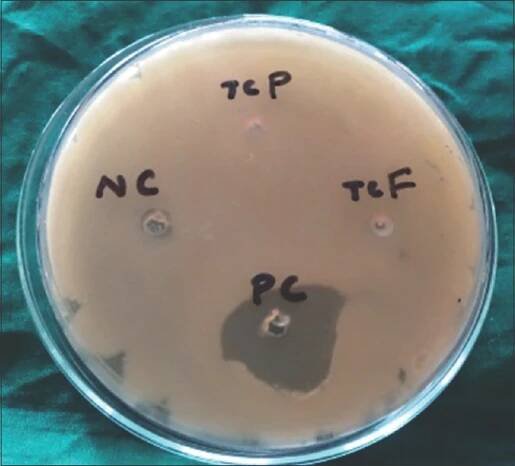

Streptococcus mutans
Bakterie
Streptococcus mutans je druh bakterie, která obvykle žije v ústní dutině člověka. Tato bakterie se přichycuje na zubech a vylučuje žíravou kyselinu. Toto přichycení umožňuje sacharidový polymer, který tvoří hlavní součást zubního plaku. Bakterie Streptococcus mutans se obvykle přenášejí z dospělých na děti a po přesunu se v ústech usadí a napadají nově se vytvářející… Wikipedia
Lidé také hledají
Streptococcus mutans – Wikipedie
Bakterie Streptococcus mutans se obvykle přenášejí z dospělých na děti a po přesunu se v ústech usadí a napadají nově se vytvářející zuby.
Streptococcus mutans - Wikipedia
Streptococcus mutans is a facultatively anaerobic, gram-positive coccus (round bacterium) commonly found in the human oral cavity and is a significant contributor to tooth decay. [1 ] [2 ] The microbe was first described by James Kilian…
Streptococcus mutans - Profimed.cz
Streptococcus mutans je druhem bakterií, které žijí v ústní dutině člověka a jsou součastí jeho ústní bakteriální mikroflóry. Velmi významně se podílí na vzniku zubního kazu, a proto jsou řazeny mezi tzv.
Streptokok – infekce, příznaky a léčba | BENU.cz
Které nemoci může streptokok způsobit a jaká jsou rizika, léčba a možnosti prevence streptokokových infekcí? Vše podstatné jsme vás shrnuli v našem článku.
Může 14 letá dcera použít na streptokoka v krku Tantum Verde ve spreji?
Dobrý den, doporučila bych spíš pastilky Strepsils Med a Citron, které obsahují léčivé látky dichlorbenzylalkohol a amylmetakresol, které mají antiseptické účinky a ničí bakterie, viry a kvasinky způsobující bolest v krku a záněty v ústní dutině. je však možné, že bude potŕeba nasadit i antibiotika. Doporučuji užívat 3-4 dny strepsils a v případě, že nenastane zlepšení, doporučuji návštěvu lékaře a domluvit se o další léčbě https://www.benu.cz/strepsils-med-a-citron-oralni-podani-pastilka-24 S pozdravem Mgr. Veronika Hajduková Farmaceut specialistaCo na bolest v krku a chycené mandle?
Dobrý den,přípravek Orofar jako lokální přípravek při bolesti v krku má nejen antiseptický (dezinfekční) účinek, ale obsahuje i lokální anestetikum - lidokain, který dutinu ústní znecitlivuje. Strepfen účinkuje obdobně, jak proti bolesti, tak navíc působí i proti zánětu.
Na trhu je ovšem řada dalších lokálních antiseptik a výběr se řídí podle konkrétního zdravotního stavu. Záleží zda se již léčíte např. antibiotiky, zda máte teplotu nad 38°C více než 3 dny, zda je bolest jen jednostranná a také, zda jste na něco alergický. Více: Jak poznat angínu
Ideálně by bylo vhodné navštívit kamennou lékárnu, kde vám zkušený a proškolený personál vybere přípravek přímo vám na míru.
S pozdravem
Mgr. Jana Učíková
vedoucí lékárník Rakovník, Husovo nám.
OPAKOVANÉ Angíny
Dobrý den,Ve Vašem případě je nezbytné posílit Vaši imunitu. Opakované angíny provázené bolestí v krku atp. jsou důsledek slabé imunity a časté braní antibiotik Vám imunitu ještě sníží.
Na zvýšení obranyschopnosti organismu a jako prevenci častých zánětů bych Vám doporučila přípravek Wobenzym, se kterým máme velmi dobré zkušenosti.
Na rozdíl od jiných léků přírodní enzymy nezasahují proti projevům anebo původci určitého onemocnění, ale mobilizují imunitní systém, aby se organismus s nemocí nebo její hrozbou vypořádal co nejlépe sám. Pokud už někoho virózy nebo angíny sužují, vyplatí se začít užívat enzymy co nejdříve, protože kromě potřebného posílení imunity Wobenzym pomáhá také rychleji zvládnout onemocnění dýchacích cest a zkracuje tak dobu léčby. Při podávání antibiotik podporuje jejich průnik do tkání a zlepšuje účinek léčby. V období rekonvalescence po skončení nemoci je účinnou obranou proti jejímu případnému opakování anebo přechodu do chronického stavu.
Při zánětech v oblasti uší, nosu, krku, horních i dolních dýchacích cest se podává Wobenzym v dávce 3×3 až 3×5 tablet denně až do odeznění příznaků (v počátku léčby dáváme přednost vyšší dávce). Tablety se užívají nalačno, 1 hodinu před jídlem s větším množstvím tekutiny.
Imunitu je důležité posilovat i zdravou stravou, přiměřeným pohybem, otužováním a vyhýbáním se stresu.
WOBENZYM
S pozdravem
Mgr. Nesrstová Kristýna
vedoucí lékárník BENU Šternberk
Streptococcus mutans | Herbadent SHOP
Streptococcus mutans je typem bakterie, která se řadí mezi tzv. kariogenní bakterie přirozeně osidlující dutinu ústní každého z nás.
Streptococcus mutans - Modrý koník
Streptococcus mutans je bakterie, která je zodpovědná za vznik a rozvoj zubního kazu. Je hlavní součástí zubního plaku.
Úloha Streptococcus mutans v orálnom biofilme | proLékaře.cz
Autoři: K. Legéňová; H. Bujdáková Působiště autorů: Univerzita Komenského v Bratislave, Prírodovedecká fakulta, Katedra mikrobiológie a virológie, Bratislava, Slovenská republika Vyšlo v časopise: Epidemiol.
Streptococcus mutans and its ability to metabolize various…
Bacteria S. mutans were optimally grown in a 5% CO2-aerobic atmosphere at 37°C on solid and liquid tryptic soy broth with cariogenic fructose, glucose, galactose, lactose, sucrose, and non-cariogenic xylitol.
Streptococcus mutans – WikiSkripta
Internetové studijní materiály pro studenty českých a slovenských lékařských fakult.
Charakteristika Streptococcus mutans, morfologie, onemocnění…
Streptococcus mutans je bakterie, která se podílí na tvorbě zubního plaku nebo biofilmu, který se tvoří na sklovině zubů. Je to
odkazuje na služby nejen od Seznam.cz.
© 1996–2025 Seznam.cz, a.s.